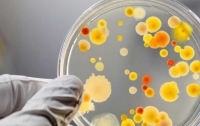
Отравление на Львовщине: в восьми жителей диагностировали сальмонеллез

ВСЕ НОВОСТИ
-
 17:55 Происшествия
17:55 Происшествия
Массовое отравление в Ровенской области: стали известны причины
-
 20:46 Происшествия
20:46 Происшествия
Названа причина массового отравления во львовском фаст-фуде
-
 19:38 Здоровье
19:38 Здоровье
Летние болезни: врачи рассказали, чего остерегаться украинцам
-
 08:33 Мир
08:33 Мир
Сальмонеллез стал причиной отравления 188 человек
-
 11:49 Происшествия
11:49 Происшествия
На Тернопольщине детей заразили сальмонеллезом
-
17:59 Здоровье
17:59 Здоровье
Отравление на Львовщине: в восьми жителей диагностировали сальмонеллез
-
 23:35 Мир
23:35 Мир
В США зарегистрирована вспышка сальмонеллеза
-
 17:05 Наука и техника
17:05 Наука и техника
Ученые раскрыли тайну гибели цивилизации ацтеков
-
 17:41 Мир
17:41 Мир
В Бурятии 125 человек отравились в кафе
-
 18:58 Происшествия
18:58 Происшествия
Массовое отравление рыбой во Львове: число пострадавших продолжает расти
-
 21:57 Происшествия
21:57 Происшествия
В Мариуполе посетители кафе заболели сальмонеллезом
-
 17:11 Здоровье
17:11 Здоровье
На Полтавщине зафиксирована вспышка сальмонеллеза, - СМИ
-
 05:31 Киев
05:31 Киев
Массовое отравление суши в столице: у повара ресторана обнаружена сальмонелла
-
 21:43 Киев
21:43 Киев
Массовое отравление суши в Киеве: у госпитализированных подозревают сальмонеллез
-
03:22 Общество
На Тернопольщине зафиксировали вспышку сальмонеллеза




